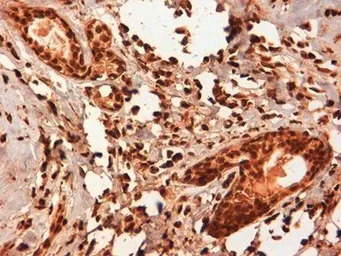
Estrogen Receptor beta 5 antib

相关产品推荐更多 >
万千商家帮你免费找货
0 人在求购买到急需产品
- 详细信息
- 文献和实验
- 技术资料
- 免疫原:
Tuberculin conjugated synthetic peptide LLSHVRHARYAP derived from the C-terminus of human ERB5.
- 亚型:
IgG1
- 形态:
Liquid
- 保存条件:
Store as concentrated solution. Centrifuge briefly prior to opening vial. For short-term storage (1-2 weeks), store at 4ºC. For long-term storage, aliquot and store at -20ºC or below. Avoid multiple freeze-thaw cycles.
- 克隆性:
Monoclonal
- 标记物:
Unconjugated
- 适应物种:
Human
- 保质期:
12 months from the shipping date of the product.
- 抗原来源:
Human
- 目录编号:
GTX41212
- 级别:
Primary Antibodies
- 库存:
Available
- 供应商:
GeneTex
- 宿主:
Mouse
- 应用范围:
WB, IHC-P
- 浓度:
1.0 mg/ml (Please refer to the vial label for the specific concentration.)
- 靶点:
Clone 5/25 specifically recognizes human estrogen receptor beta 5 (ERB5), a splice variant of the nuclear receptor hormone ER beta (ESR2), shown to exist in at least five isoforms (ERB1-ERB5).
- 抗体英文名:
Estrogen Receptor beta 5 antibody [5/25]
- 抗体名:
Estrogen Receptor beta 5 抗体 [5/25]
- 规格:
100 μg

IHC-P analysis of human breast cancer tissue using GTX41212 Estrogen Receptor beta 5 antibody [5/25].
IHC-P analysis of human breast cancer tissue using GTX41212 Estrogen Receptor beta 5 antibody [5/25].
风险提示:丁香通仅作为第三方平台,为商家信息发布提供平台空间。用户咨询产品时请注意保护个人信息及财产安全,合理判断,谨慎选购商品,商家和用户对交易行为负责。对于医疗器械类产品,请先查证核实企业经营资质和医疗器械产品注册证情况。
 文献和实验
文献和实验secondary antibody review -- data from 99 publications
cytometry used as a control to detect cell responses targeted antigen 7 Alexa Fluor 488 7 Cy3 8 goat IgG Alexa Fluor 488 1:2000 detect antibody binding in human embryonic kidney 293T cells Invitrogen 9 donkey
Characterization of Nuclear Receptor Ligands by Multiplexed Peptide Interactions
.P., and Schatz, P.J. 2000. Selection of estrogen receptor beta‐ and thyroid hormone receptor beta‐specific coactivator‐mimetic peptides using recombinant peptide libraries. Mol. Endocrinol. 14:605‐622.
祝贺〖雅裕睿安〗成为Signalway Antibody(SAB)独家
Xia''Xiang Gao''Zhimin Lu''et al.(2009) FAK Phosphorylation by ERK Primes Ras-Induced Tyrosine Dephosphorylation of FAK Mediated by PIN1 and PTP-PEST.Molecular Cell''35:11–25 3.J Bossuyt''K Helmstadter''X Wu''et al.(2008) u Ca
 技术资料
技术资料暂无技术资料 索取技术资料







![Adenosine kinase antibody [N1C1]](https://img1.dxycdn.com/2022/0328/894/7474865433004200453-14.jpg!wh200)
![S100A8 antibody [CF-145]](https://img1.dxycdn.com/2022/0328/536/4216183960637300453-14.jpg!wh200)
![CD92 antibody [VIM15] (PE)](https://custom.dxycdn.com/trademd/upload/pic/2013/11/12/A1383891150.jpg!small.t.1)

